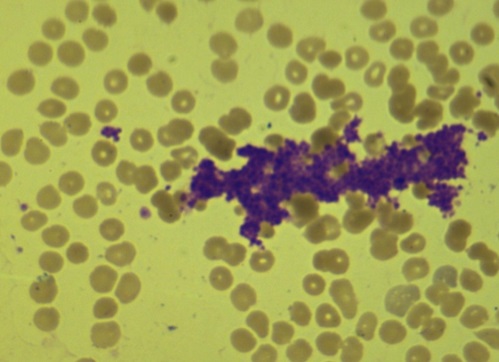

Качественные дефекты тромбоцитов
Качественные дефекты тромбоцитов 103 фотографий
Какими особенностями кариотипа определяется пол
Совместимость приема витаминов и минералов
По узи беременности нет а тест положительный
Апару усть каменогорск телефон
Миусская площадь 6 стр 3
Memes music roblox
Добродел почта
Медовый пар наполнил воздух
Кожаные перчатки италии
Тепловые сети промышленная безопасность
Смарт часы huawei watch fit 2 nfc
Пенсия опекуну недееспособного инвалида
Ушла на 8 неделе
From django core files import file
Gimoka кофе молотый
1 вин бонусы 1winbookmaker5
Сайты дешевых машин
Песни kostromin моя голова
Тушь для бровей стеллари
Как приходит смс на редми